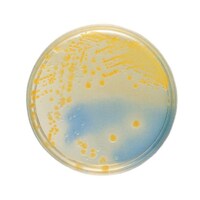
���{�x�N�g���E�f�B�b�L���\���@�a�c�@�a�a�k�i�s�l�j�@�b�k�d�c���V�|�n�@�Q�O��

日本ベクトン・ディッキンソン BD BBL(TM) ブリューワー変法チオグリコレート培地 211716 1個
偏性嫌気性菌、微好気性菌および培養条件が難しい細菌の培養に使用します。
偏性嫌気性菌、微好気性菌および培養条件が難しい細菌の培養に使用します。+もっと見る
日本ベクトン・ディッキンソン BD BBL(TM) マッコンキーII寒天培地 20枚
マッコンキーII 寒天培地は臨床材料からグラム陰性桿菌の選択分離培地として用いられます
マッコンキーII 寒天培地は臨床材料からグラム陰性桿菌の選択分離培地として用いられます+もっと見る
日本ベクトン・ディッキンソン BD BBL(TM) BTB乳糖加寒天培地 100枚
BTB 乳糖加寒天培地は臨床材料から、特にグラム陰性桿菌の分離用に使用します
BTB 乳糖加寒天培地は臨床材料から、特にグラム陰性桿菌の分離用に使用します+もっと見る
Merck 粉末培地 (フレーザー・リステリア増菌ブイヨン基礎培地) 500g 1.10398.0500
粉末培地 (フレーザー・リステリア増菌ブイヨン基礎培地) 500g は信頼と実績に優れた商品です。
粉末培地 (フレーザー・リステリア増菌ブイヨン基礎培地) 500g は信頼と実績に優れた商品です。+もっと見る
スリーエム ジャパン ペトリフィルム(TM)培地 スプレッダー2個入 6425 培地 簡易培地 1箱(2個入)
接種した検液を均一に広げるためのスプレッダーです。
接種した検液を均一に広げるためのスプレッダーです。+もっと見る
日本ベクトン・ディッキンソン BD Difco(TM) MUG添加ニュートリエント寒天培地 223200 分析・検査 培地 1個
水中の大腸菌の検出および菌数測定を発光酵素基質法で検出します。
水中の大腸菌の検出および菌数測定を発光酵素基質法で検出します。+もっと見る
日本ベクトン・ディッキンソン BD Difco(TM) ニュートリエント寒天培地1.5% 269100 培地 その他 1個
血液または他のエンリッチメントを添加して、培養条件の難しい微生物の培養に使用します。
血液または他のエンリッチメントを添加して、培養条件の難しい微生物の培養に使用します。+もっと見る
日本ベクトン・ディッキンソン BD Difco(TM) ルリアブロス基礎培地ミラー 241420 培地 その他 1個
分子生物学試験で使用する大腸菌の増殖および保存用の基礎液体培地です。
分子生物学試験で使用する大腸菌の増殖および保存用の基礎液体培地です。+もっと見る
日本ベクトン・ディッキンソン BD Difco(TM) サルファイト寒天培地 297210 培地 その他 1個
特に食品中の硫化水素を産生する好温性嫌気性菌の検出用です。
特に食品中の硫化水素を産生する好温性嫌気性菌の検出用です。+もっと見る
日本ベクトン・ディッキンソン BD Difco(TM) リジン脱炭酸ブロス 211759 分析・検査 培地 1個
リジン脱炭酸能により、腸内細菌を鑑別するのに使用される培地です。
リジン脱炭酸能により、腸内細菌を鑑別するのに使用される培地です。+もっと見る
日本ベクトン・ディッキンソン BD Difco(TM) ノーブル寒天 500g 214230 分析・検査 培地 1個
高純度が要求される電気泳動および物質代謝の検査に使用します。
高純度が要求される電気泳動および物質代謝の検査に使用します。+もっと見る
日本ベクトン・ディッキンソン BD Difco(TM) デソキシコール酸ナトリウム 224820 培地 その他 1本
肺炎球菌の胆汁溶解性試験用および培地成分として使用されるデソキシコレートのナトリウム塩です。
肺炎球菌の胆汁溶解性試験用および培地成分として使用されるデソキシコレートのナトリウム塩です。+もっと見る
日本ベクトン・ディッキンソン BD Difco(TM) エルシニア抗生物質サプリメント CN 1個(6本入) 231961 培地 その他 1個(6本)
Y.enterocoliticaの選択的分離培地と共に使用します。
Y.enterocoliticaの選択的分離培地と共に使用します。+もっと見る
日本ベクトン・ディッキンソン BD Difco(TM) 粉末ティンスダールエンリッチメント 1個(6本入) 234210 培地 その他 1個(6本)
ジフテリア菌の鑑別的分離に用いるティンスダール基礎培地と共に使用します。
ジフテリア菌の鑑別的分離に用いるティンスダール基礎培地と共に使用します。+もっと見る
日本ベクトン・ディッキンソン BD Difco(TM) マイコプラズマサプリメント 1個(6本入) 283610 分析・検査 培地 1個(6本)
マイコプラズマの分離培養に用いるマイコプラズマ培地(PPLO培地)と共に使用します。
マイコプラズマの分離培養に用いるマイコプラズマ培地(PPLO培地)と共に使用します。+もっと見る
日本ベクトン・ディッキンソン BD Difco(TM) 濃縮ぺナーゼ 1個(10本入) 215332 分析・検査 培地 1個(10本)
βラクタム環を解裂し、ペニシリンを不活化します。
βラクタム環を解裂し、ペニシリンを不活化します。+もっと見る
日本ベクトン・ディッキンソン BD Difco(TM) サプリメントB 1個(6本入) 227610 培地 その他 1個(6本)
栄養要求の厳しい細菌の培養用培地に添加し使用します。
栄養要求の厳しい細菌の培養用培地に添加し使用します。+もっと見る
Merck SCDブイヨン 培地充填試験用顆粒培地 500g (動物由来成分・含) 1.00800.0500 培地 培地(食品検査用) 1本
培地充填試験に使用できます。
培地充填試験に使用できます。+もっと見る
Merck SCDブイヨン 培地充填試験用顆粒培地 500g (動物由来成分・不含) 1.00550.0500 培地 培地(食品検査用) 1本
培地充填試験に使用できます。
培地充填試験に使用できます。+もっと見る
Merck SCDブイヨン 培地充填試験用顆粒培地 5kg (動物由来成分・不含) 1.00550.5000 培地 培地(食品検査用) 1箱
培地充填試験に使用できます。
培地充填試験に使用できます。+もっと見る
アズワン サニスペック粉末培地 デソキシコレート寒天・顆粒 4112602 培地 1個
アズワンの「サニスペック粉末培地 デソキシコレート寒天・顆粒」は、品質と信頼性に優れた人気商品です。
アズワンの「サニスペック粉末培地 デソキシコレート寒天・顆粒」は、品質と信頼性に優れた人気商品です。+もっと見る
日本ベクトン・ディッキンソン BD ロダック(TM) プレート CP添加ポテト寒天培地 1個(1本×30枚入)
食品製造環境及び調理、従事者向けのスタンプ式の培地です。
食品製造環境及び調理、従事者向けのスタンプ式の培地です。+もっと見る
日本ベクトン・ディッキンソン BD BBL(TM) BYチョコレート寒天培地 20枚
BYチョコレート寒天培地は臨床材料からHaemophilus, Neisseriaなどの栄養要求の厳しい細菌の分離培養に用いられます
BYチョコレート寒天培地は臨床材料からHaemophilus, Neisseriaなどの栄養要求の厳しい細菌の分離培養に用いられます+もっと見る
日本ベクトン・ディッキンソン BD BBL(TM) SCD寒天培地 RT 1個(1本×100枚入)
日本薬局方の微生物限度試験など用で、常温保存で6か月の有効期限です。
日本薬局方の微生物限度試験など用で、常温保存で6か月の有効期限です。+もっと見る
日本ベクトン・ディッキンソン BD BBL(TM) チョコレートII寒天培地 20枚
チョコレートII 寒天培地は臨床材料からHaemophilus, Neisseria などの栄養要求の厳しい細菌の分離培養に用いられます
チョコレートII 寒天培地は臨床材料からHaemophilus, Neisseria などの栄養要求の厳しい細菌の分離培養に用いられます+もっと見る
日本ベクトン・ディッキンソン BD BBL(TM) チョコレートII寒天培地 100枚
チョコレートII 寒天培地は臨床材料からHaemophilus, Neisseria などの栄養要求の厳しい細菌の分離培養に用いられます
チョコレートII 寒天培地は臨床材料からHaemophilus, Neisseria などの栄養要求の厳しい細菌の分離培養に用いられます+もっと見る
Merck 粉末培地 (カンピロバクター無血液選択寒天基礎培地) 500g 1.00070.0500
粉末培地 (カンピロバクター無血液選択寒天基礎培地) 500g は信頼と実績に優れた商品です。
粉末培地 (カンピロバクター無血液選択寒天基礎培地) 500g は信頼と実績に優れた商品です。+もっと見る
日本ベクトン・ディッキンソン BD Difco(TM) マイクロイノキュラムブロス 211813 培地 その他 1個
ビタミンおよびアミノ酸の微生物学的分析法で用いる乳酸桿菌および他の微生物の培養に使用します。
ビタミンおよびアミノ酸の微生物学的分析法で用いる乳酸桿菌および他の微生物の培養に使用します。+もっと見る
日本ベクトン・ディッキンソン BD Difco(TM) ノボビオシンサプリメント 1個(6本入) 231971 培地 その他 1個(6本)
大腸菌O157の増菌用に用いる変法EC培地と共に使用します。
大腸菌O157の増菌用に用いる変法EC培地と共に使用します。+もっと見る
日本ベクトン・ディッキンソン BD Difco(TM) レプトスピラエンリッチメントEMJH 1個(6本入) 279510 分析・検査 培地 1個(6本)
(レプトスピラの培養および保存に用いる)レプトスピラ基礎培地EMJHと共に使用します。
(レプトスピラの培養および保存に用いる)レプトスピラ基礎培地EMJHと共に使用します。+もっと見る
日本ベクトン・ディッキンソン BD Difco(TM) MツベルクローシスH37RA 1個(6本入) 231141 分析・検査 培地 1個(6本)
粉末化した不活化済み結核菌体H37Raです。
粉末化した不活化済み結核菌体H37Raです。+もっと見る
Merck 粉末培地 クロストリジウム選択寒天培地 亜硫酸塩還元性クロストリジウム 1.10259.0500
粉末培地 クロストリジウム選択寒天培地 亜硫酸塩還元性クロストリジウム は信頼と実績に優れた商品です。
粉末培地 クロストリジウム選択寒天培地 亜硫酸塩還元性クロストリジウム は信頼と実績に優れた商品です。+もっと見る
日本ベクトン・ディッキンソン BD BBL(TM) DHL寒天培地 20枚
DHL寒天培地は、病原性腸内細菌の選択分離用の培地で、特にSalmonella、Shigella、Y. enterocoliticaなどの分離を目的とします
DHL寒天培地は、病原性腸内細菌の選択分離用の培地で、特にSalmonella、Shigella、Y. enterocoliticaなどの分離を目的とします+もっと見る
日本ベクトン・ディッキンソン BD ロダック(TM) プレート CP添加サブロー寒天培地 1個(1本×30枚入)
食品製造環境及び調理、従事者向けのスタンプ式の培地です。
食品製造環境及び調理、従事者向けのスタンプ式の培地です。+もっと見る
日本ベクトン・ディッキンソン BD BBL(TM) DHL寒天培地 100枚
DHL寒天培地は、病原性腸内細菌の選択分離用の培地で、特にSalmonella、Shigella、Y. enterocoliticaなどの分離を目的とします
DHL寒天培地は、病原性腸内細菌の選択分離用の培地で、特にSalmonella、Shigella、Y. enterocoliticaなどの分離を目的とします+もっと見る
栄研化学 粉末(特包粉末) BCP加プレートカウント寒天培地 1箱(6袋入) EKB41
乳酸菌数測定用1回の使用量の多い場合に適しています。
乳酸菌数測定用1回の使用量の多い場合に適しています。+もっと見る
Merck 粉末培地 (カンピロバクターCCDA選択剤) 10バイアル 1セット(10本入) 1.00071.0010
粉末培地 (カンピロバクターCCDA選択剤) 10バイアル 1セット(10本入) は信頼と実績に優れた商品です。
粉末培地 (カンピロバクターCCDA選択剤) 10バイアル 1セット(10本入) は信頼と実績に優れた商品です。+もっと見る
日本ベクトン・ディッキンソン BD Difco(TM) スピリットブルー寒天培地 500g 295020 分析・検査 培地 1個
リパゼ試薬を添加して、脂肪分解性微生物の菌数測定および検出に使用します。
リパゼ試薬を添加して、脂肪分解性微生物の菌数測定および検出に使用します。+もっと見る
日本ベクトン・ディッキンソン BD Difco(TM) レジオネラ寒天培地エンリッチメント 1個(6本入) 233901 培地 その他 1個(6本)
(レジオネラの分離および培養に用いる)レジオネラ寒天基礎培地と共に使用します。
(レジオネラの分離および培養に用いる)レジオネラ寒天基礎培地と共に使用します。+もっと見る
スリーエム ペトリフィルム(TM)培地 (水中一般生菌数測定用/50枚×2袋) 6450AQHC 培地 簡易培地 1箱(2袋)
検査工程が容易で、標準化する事が可能。
検査工程が容易で、標準化する事が可能。+もっと見る
スリーエム ペトリフィルム(TM)培地 (水中一般生菌数測定用/50枚×20袋) 6452AQHC 培地 簡易培地 1箱(20袋)
検査工程が容易で、標準化する事が可能。
検査工程が容易で、標準化する事が可能。+もっと見る
Merck クリーンルーム用環境測定培地 1ケース(20枚入) SCD ICR90 培地 培地(食品検査用) 1ケース(20枚)
耐乾燥性に優れ、培地表面がひび割れにくいです。
耐乾燥性に優れ、培地表面がひび割れにくいです。+もっと見る
極東製薬工業 バイタルメディア 変法スキロー寒天培地 20枚 05547 培地 培地(食品検査用) 1箱(20枚)
培地調製の手間が省け、ムダがありません。
培地調製の手間が省け、ムダがありません。+もっと見る
Merck 無菌試験用液体培地 チューブ SCD液体培地 LTHTh 1箱(20本入) 1.46283.0020 培地 培地(食品検査用) 1箱(20本)
無菌試験専用の液体培地です。
無菌試験専用の液体培地です。+もっと見る
Merck リステリア測定用培地 クロモカルトリステリア(ALOA寒天培地) リステリアの選択培地 1.00427.0500
Readybag(R)で一次増菌を行った後、選択増菌及び選択分離を行います。
Readybag(R)で一次増菌を行った後、選択増菌及び選択分離を行います。+もっと見る
日本ベクトン・ディッキンソン BD BBL(TM) CLED寒天培地 20枚
CLED寒天培地は、尿中細菌の定量と分離培養に適しており、尿路感染症を診断するのに推奨されます
CLED寒天培地は、尿中細菌の定量と分離培養に適しており、尿路感染症を診断するのに推奨されます+もっと見る
エルメックス XgalMUG培地
+もっと見る
極東製薬工業 生培地(バイタルメディア) TCBS寒天培地 ビブリオ分離用 20枚入 05691
高品質の生培地です。培地調製の手間が省け、ムダがありません。
高品質の生培地です。培地調製の手間が省け、ムダがありません。+もっと見る
Merck 粉末培地 (クロモカルトコリフォーム寒天ES) 500g 1.00850.0500 培地 培地(食品検査用) 1個
Merckの「粉末培地 (クロモカルトコリフォーム寒天ES) 500g」は、品質と信頼性に優れた人気商品です。
Merckの「粉末培地 (クロモカルトコリフォーム寒天ES) 500g」は、品質と信頼性に優れた人気商品です。+もっと見る